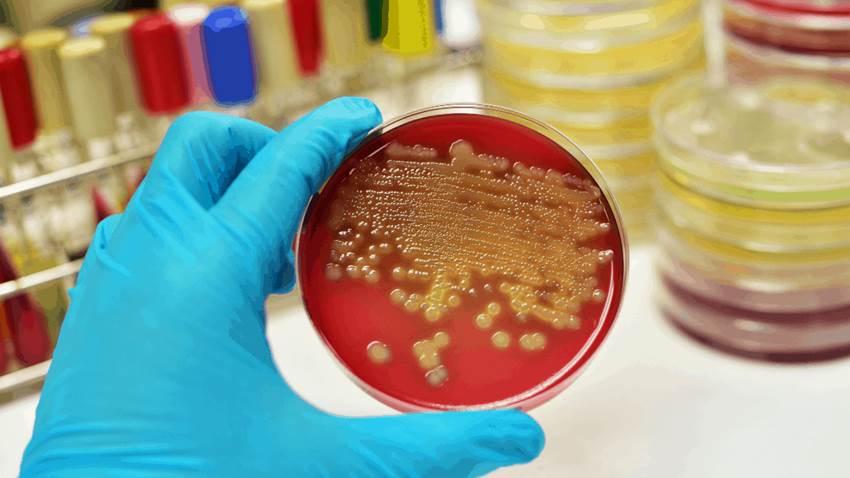
Creada una cepa sintética de la bacteria Escherichia coli resistente a los virus

La fusión entre las vacunas AstraZeneca y Pfizer potencia respuesta inmunitaria contra el COVID-19
El estudio CombivacS, realizado por investigadores del Instituto de Salud Carlos III (ISCIII) de España, está evaluando una fusión de vacunación contr...